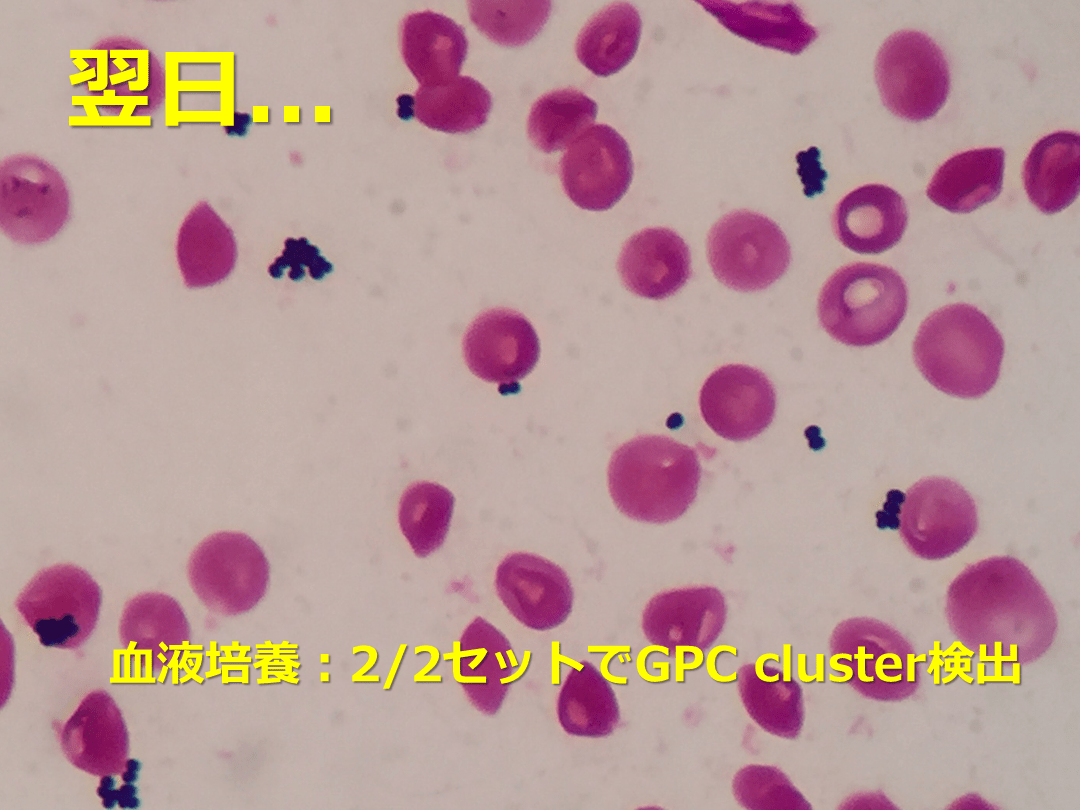

1/187
関連するスライド
グラム陽性桿菌 オーバービュー
わかやま
9460
40
アフリカにおける感染症対策
黒田浩一
72763
48
発熱性好中球減少症とは?
日本臨床腫瘍学会
1891
10
その他の抗菌薬 -フルオロキノロン,テトラサイクリン,マクロライド-
高野哲史
24460
85
発熱性好中球減少症 Febrile Neutropenia
1,185,715
738
概要
発熱性好中球減少症の講義スライドです。特に好中球減少患者における感染症予防の項目に力を入れて作成しました。第3回亀田感染症セミナー in 東京(2018年8月26日開催)で使用する予定のものです。
本スライドの対象者
研修医/専攻医
投稿された先生へ質問や勉強になったポイントをコメントしてみましょう!
0 件のコメント
黒田浩一さんの他の投稿スライド
市中肺炎診療の考え方 ウィズコロナ時代
黒田浩一
573,053
409
免疫抑制・化学療法によるB型肝炎ウイルス再活性化への対策
黒田浩一
36,729
285
COVID-19治療 アップデート 2023年9月版
黒田浩一
1,090,094
1,010
このスライドと同じ診療科のスライド
テキスト全文
発熱性好中球減少症の概要と目的
#1.
発熱性好中球減少症Febrile Neutropenia(FN) 亀田総合病院感染症科 黒田浩一 第3回KINDセミナー 2018.8.26
#2.
本日の内容 がん薬物療法中の患者の感染症予防 FNの定義 FN患者の重症化のリスク評価 FNの初期治療 FNの初期治療の変更 FNの治療期間
#3.
本日の到達目標 がん薬物療法中の予防的抗菌薬・抗真菌薬・抗ウイルス薬の適応を理解する FNの定義を理解する FN患者の重症化リスク評価を理解する FNの治療を理解する FNの治療期間を理解する
急性骨髄性白血病の症例紹介
#4.
症例:50歳台男性 【現病歴】 入院1週間前にふらつきで他院受診。精査の結果、急性骨髄性白血病と診断された。寛解導入療法(IDA+Ara-C)目的で当院入院となった。 注意:想像上の症例ですので、講義のものと若干異なります
#5.
症例:50歳台男性 【既往歴】 2型糖尿病(HbA1c 7.2%) 【薬剤歴】 メトグルコ、ジャヌビア、ピオグリタゾン フルコナゾール、アシクロビル 【社会歴】 喫煙:20本/日を30年間程度(現喫煙者) 飲酒:なし 【アレルギー】 なし
#6.
質問1この患者においてがん化学療法中の感染症予防はどうしますか?
がん化学療法中の感染症予防
#7.
追加情報 過去3か月の白血球数 白血球:1,400 /μL 好中球:100 /μL 入院時の白血球 白血球:1,500 /μL 好中球:120 /μL HSV抗体陽性、VZV抗体陽性
#8.
問題 予防の対象は(複数回答可)? ①細菌感染症 ②真菌感染症 ③ヘルペスウイルス属 ④ニューモシスチス肺炎
#9.
感染症予防 細菌感染症 侵襲性真菌感染症 Candida spp. Aspergillus spp. PCP ウイルス感染症 HSV・VZV・HBV
#10.
抗菌薬の予防投与
抗菌薬の予防投与とガイドライン
#11.
抗菌薬の予防投与 high-risk患者 = 好中球100/μl以下の状態が7日以上予想される - フルオロキノロンの予防内服を考慮 - レボフロキサシンまたはシプロフロキサシン low-risk患者(好中球減少期間が7日未満) - 予防投与を推奨しない Clin Infect Dis 2011;52:e56-93 FQ:Fluoroquinolone フルオロキノロン
#12.
抗菌薬の予防投与:補足 レボフロキサシンが好まれる場合 - 口腔内の粘膜炎に関連したViridans Group Streptococcusによる侵襲性感染症のリスクが高い場合 グラム陰性桿菌のFQ耐性のモニタリング が推奨される Clin Infect Dis 2011;52:e56-93 FQ:Fluoroquinolone フルオロキノロン
#13.
各ガイドラインの推奨 各ガイドラインでの推奨はほぼ同じ IDSA 2011(米国感染症学会) 好中球100 /μL以下が7日より長期間予想される場合 ASCO 2013(米国臨床腫瘍学会) 好中球100 /μL未満が7日以上予想される場合 GNRのFQ耐性が20%を超える場合効果が乏しい可能性 NCCN 2018(National Comprehensive Cancer Network) 好中球1,000 /μL未満が7日より長期間予想される場合 日本臨床腫瘍学会 2017 好中球100 /μL未満が7日より長期間予想される場合 IDSA:Infectious Diseases Society of America, ASCO:American Society of Clinical Oncology, GNR:Gram-Negative Rods
#14.
抗菌薬予防投与の効果 全死亡・感染症関連死亡・FN・微生物学的または臨床的に確定した感染症が減少したmeta-analysisがある。 LVFXの予防効果を評価したRCTでは、FN・微生物学的に確定した感染症・菌血症が減少したが、死亡率は低下しなかった キノロン耐性E. coliとCDIの増加に関連している可能性が指摘されているが、FQ耐性菌のcolonizationは増えたが、FQ耐性菌による感染症は増加しなかったという報告もある N Engl J Med 2005;353:977-87 Ann Intern Med 2005;142:979-95 Clin Infect Dis 2011;52:e56-e93 J Antimicrob Chemother 2007;59:5-22 FQ:Fluoroquinolone フルオロキノロン
抗真菌薬の予防投与の適応と選択
#15.
抗菌薬予防投与の効果 FNと菌血症などの微生物学的に確定した感染症は減少する 全死亡率と感染症関連死亡率が改善する可能性がある キノロン耐性グラム陰性桿菌が増加する可能性がある
#16.
抗菌薬の選択と投与期間 以下のフルオロキノロンを選択 レボフロキサシン 500mg/日 シプロフロキサシン 500mg×2/日 投与期間 開始:化学療法開始日 終了:好中球回復 or FN発症時点 Clin Infect Dis 2011;52:e56-e93 NCCN guideline Version 1.2018 Prevention and Treatment of Cancer-related infection
#17.
反対意見もある オーストラリアのガイドライン 血液悪性腫瘍の化学療法の場合でも、予防的フルオロキノロンの投与「すべきでない」 内科病棟におけるE. coliのキノロン耐性率が20%を越える場合は、予防投与のベネフィットは失われる 使用反対の理由 (FNは減るが...)全死亡率を低下させる根拠に欠ける グラム陰性桿菌の耐性化、Clostridium difficile感染症増加の懸念、コスト増大の可能性 Intern Med J 2011;41:102-109 日本のほとんどの医療施設で E. coliのFQ感受性率80%以下
#18.
実際どうする? 基本はレボフロキサシン投与 院内アンチバイオグラムを作成 - 毎年更新する - E. coliのキノロン感受性の推移をみる キノロン耐性率が高い場合は、予防内服を行わないほうがよいかもしれない
侵襲性真菌感染症の予防と治療
#19.
抗真菌薬の予防投与
#20.
ポイント 予防投与の適応 抗真菌薬の選択 - 基本はCandida予防 - Aspergillusもカバーするか
#21.
コンセプト
#22.
抗真菌薬の予防投与 侵襲性Candida感染症の発生率が10%を越える場合に、Candida感染予防を行う 侵襲性Aspergillus感染症の発生率が6-8%を越える場合に、糸状菌に効果のある抗真菌薬を選択する Clin Infect Dis 2011;52:e56-93, J Clin Oncol 2013;31:794-810 J Antimicrob Chemother. 2018 Aug 1. doi: 10.1093/jac/dky286. [Epub ahead of print]
各ガイドラインの推奨と比較
#23.
基本はCandida予防
#24.
抗真菌薬の予防投与 侵襲性カンジダ感染症のリスクが非常に高い患者 - 同種造血幹細胞移植 - 急性白血病に対する強化寛解導入療法 - 急性白血病に対するサルベージ導入療法 で、カンジダ感染予防が推奨される(A-I) Clin Infect Dis 2011;52:e56-93
#25.
Candida感染症予防薬 フルコナゾール イトラコナゾール ボリコナゾール ミカファンギン ポサコナゾール カスポファンギン どれも受け入れられる選択肢、と記載されている Clin Infect Dis 2011;52:e56-93
#26.
抗真菌薬の予防投与 好中球減少期間が7日未満の場合 - 抗真菌薬の予防内服は行わない(A-III) Clin Infect Dis 2011;52:e56-93
#27.
いつAspergillus?
#28.
Aspergillus予防 AMLまたはMDSに対する強化化学療法 - 13歳以上の患者 - IAのリスクが極めて高い場合 - ポサコナゾールを考慮すべき(B-I) 注意:日本では使用できない Clin Infect Dis 2011;52:e56-93 IA:invasive aspergillosis(侵襲性アスペルギルス症)
#29.
Aspergillus予防 生着前の同種または自家移植施行患者 アスペルギルス感染予防の有効性は証明されていない 以下の場合、抗糸状菌活性のある抗真菌薬を投与 - 侵襲性アスペルギルス症の既往がある場合(A-III) - 2週間以上の持続的な好中球減少が予想される場合(C-III) - HSCT前に持続的な好中球減少が認められた患者(C-III) Clin Infect Dis 2011;52:e56-93 HSCT:hematopoietic stem cell transplantation 造血幹細胞移植
#30.
各ガイドラインの比較 各ガイドラインの推奨はほぼ同じ IDSA 2011 侵襲性真菌感染症のリスクが高い場合 ASCO 2013 好中球100 /μL未満が7日以上予想される NCCN 2017 詳細な場合分けをして推奨(一覧表がある) 日本臨床腫瘍学会 2017 好中球100 /μL未満が7日より長期間予想される
抗真菌薬の選択と投与方法
#31.
Evidence
#32.
Evidence フルコナゾール ●AMLの導入療法と自家移植 侵襲性真菌感染症↓ 真菌感染症関連死亡↓ ●同種骨髄移植患者(移植後day75まで) 侵襲性真菌感染症↓ 真菌感染症関連死亡↓ 全死亡率↓(報告による) 長期生存率↑と重度の腸管GVHD↓の可能性 Clin Infect Dis 1999;28:331-340 N Engl J Med 1992;326:845-851 J Infect Dis 1995;171:1545-1552 Blood 2000;96:2055-2061
#33.
Evidence ボリコナゾール ●同種造血幹細胞移植(GVHD risk低い群) VRCZとFLCZの無作為比較試験 糸状菌感染のintensive monitoring+ ・結果 fungal-free survival 同等 over-all survival 同等 Blood 2010;116:5111-5118
#34.
Evidence ポサコナゾール 日本では認可されていない・予防投与のみでEvidenceがある ●AMLまたはMDSの寛解導入療法 FLCZ or ITCZとの無作為比較試験 侵襲性真菌感染症↓ 侵襲性アスペルギルス症↓ 全死亡率↓ ●同種造血幹細胞移植後のGVHD FLCZとの無作為比較試験 侵襲性真菌感染症→、全死亡率→ 侵襲性アスペルギルス症↓ N Engl J Med 2007;356:348-59 N Engl J Med 2007;356:335-47
#35.
Evidence ミカファンギン 副作用と薬物相互作用が少ないのが利点 内服製剤がないのが欠点 ●同種または自家造血幹細胞移植 FLCZ 400mg/dとMCFG 50mg/d無作為比較試験 治療成功率(全身真菌感染症)がFLCZより優れていた 生存率は同等 Clin Infect Dis 2004; 39:1407–16
#36.
NCCN guideline 2017 FLCZ, MCFG, VRCZ VRCZ FLCZ, MCFG, VRCZ FLCZ, MCFG day 75まで
#37.
結局どの薬剤がよい? 最新のガイドラインでは J Antimicrob Chemother. 2018 Aug 1. doi: 10.1093/jac/dky286. [Epub ahead of print]
#38.
AML/MDSの寛解導入療法 ポサコナゾール:A-I フルコナゾール:B-I イトラコナゾール(2.5mg/kg 1日2回):B-I ボリコナゾール:B-II エキノキャンディン:C-II J Antimicrob Chemother. 2018 Aug 1. doi: 10.1093/jac/dky286. [Epub ahead of print]
#39.
自家造血幹細胞移植 侵襲性真菌感染症のリスクは低い フルコナゾールの使用を考慮(B-III) J Antimicrob Chemother. 2018 Aug 1. doi: 10.1093/jac/dky286. [Epub ahead of print]
#40.
同種造血幹細胞移植:生着前 フルコナゾール:A-I - 侵襲性真菌感染症へのpre-emptive therapy or empiric therapyと組み合わせる。施設内の糸状菌感染症の頻度が高い場合は、下記の薬剤を検討する。 イトラコナゾール:B-I ボリコナゾール:B-I ミカファンギン:B-I J Antimicrob Chemother. 2018 Aug 1. doi: 10.1093/jac/dky286. [Epub ahead of print]
PCPの予防と治療法
#41.
同種造血幹細胞移植:生着後 著明なGVHDの場合 - フルコナゾールは使用しない:A-III - ポサコナゾール:A-I - イトラコナゾール:B-I - ボリコナゾール:B-I - ミカファンギン:C-II J Antimicrob Chemother. 2018 Aug 1. doi: 10.1093/jac/dky286. [Epub ahead of print] 侵襲性糸状菌感染症 のリスクが高い
#42.
まとめ(日本では...) AML/MDS導入療法 FLCZ<ポサコナゾール(VRCZが代替薬?) 自家移植(粘膜障害あり) FLCZまたはMCFG(内服困難時) 同種移植 生着前:FLCZまたはMCFGが第1選択 糸状菌感染のリスクが高い場合は、VRCZ 生着後(著明なGVHD):VRCZまたはITCZ
#43.
抗真菌薬の投与方法と投与期間 フルコナゾール 400mg/日 ボリコナゾール 200mg×2/日 ミカファンギン 50-100mg/日(点滴) イトラコナゾール 200mg(2.5mg/kg)×2/日 投与終了のタイミング - 好中球回復(同種HSCTの場合は移植後75日まで) - 著明なGVHDが改善するまで NCCN guideline Version 1.2018 Prevention and Treatment of Cancer-related infection
#44.
TDMは必要か? フルコナゾール:TDM不要 VRCZ・ITCZ:トラフ濃度測定を行う ITCZ:予防 0.5 μg/mL, 治療 1-2 μg/ml VRCZ:予防 0.5-2.0 μg/mLと記載されている - 実際は1 μg/mL以上を目標とする - 食事によって吸収が低下する →食事と前後1時間以上間隔をあけて内服 NCCN guideline Version 1.2018 Prevention and Treatment of Cancer-related infection
#45.
PCPの予防(ニューモシスチス肺炎)
#46.
PCP予防 IDSA 2011では言及がない ガイドラインによって多少の違いがある PCP発症のリスクが3.5%を超える場合を予防内服の適応とする 内服継続困難な副作用は3.1% J Clin Oncol 2013;31:794-810, Cochrane Database Syst Rev. 2014;(10):CD005590 日本臨床腫瘍学会編 FN診療ガイドライン改訂第2版, 2017 NCCN guideline Version 1.2018 Prevention and Treatment of Cancer-related infections
#47.
NCCNの推奨 同種HCT ALL Alemtuzumab idelalisib±rituximab 長期ステロイド投与(20mg/日以上を4週間以上) temozolomideと放射線治療の併用 プリンアナログ製剤(or T-cell depleting agents) 自家移植 NCCN guideline Version 1.2018 Prevention and Treatment of Cancer-related infections
#48.
PCPの予防薬 ST合剤 ・PCPの発症を85-91%減少させる ・PCP関連死亡率を83%低下させる ・全死亡率は変化なし 投与法:毎日(SS)、週3回(DS) - 毎日 vs 週3回は、同等 Mayo Clin Proc 2007;82:1052-9 Cochrane Database Syst Rev. 2014;(10):CD005590 J Clin Oncol 2013;31:794-810, J Antimicrob Chemother 2016;71:2397–2404 NCCN guideline Version 1.2018 Prevention and Treatment of Cancer-related infections Cochrane Database Syst Rev. 2014;(10):CD005590 SS:日本製剤1錠に該当 DS:日本の製剤2錠に該当
#49.
ST合剤週2回は? 千葉大学血液内科からの報告 観察研究 同種造血幹細胞移植後のST予防内服 SS 2錠(分2)を週2回内服 156名の患者を対象 ST合剤内服中のPCP発症はなし 副作用で内服中断した患者は2名(1.3%) Bone Marrow Transplantation 2011;46:1573-1575
#50.
ST合剤の投与期間 同種HSCT 生着から少なくともday180まで または免疫抑制薬使用期間 ALL 導入治療開始から化学療法終了まで alemtuzumab 開始から最終dose後2ヶ月 and CD4 200/μLを超えるまで フルダラビン 開始からCD4 200/μLを超えるまで 自家移植 移植後3-6か月 J Clin Oncol 2013;31:794-810 NCCN guideline Version 1.2018 Prevention and Treatment of Cancer-related infections
抗ウイルス薬の予防投与と効果
#51.
ST合剤の代替薬 ダプソン 50mg 1日2回内服 ペンタミジン吸入 300mg/回 月1回 アトバコン 1500mg 1日1回 内服 J Antimicrob Chemother 2016;71:2397–2404 Bone Marrow Transplant 1999;24:897-902
#52.
抗ウイルス薬の予防投与 HSV・VZV
#53.
HSV感染と化学療法 好中球減少患者の粘膜炎の重要な原因微生物 HSV sero-positiveの患者で、予防なしで造血幹細胞移植または急性白血病の導入療法を行うと、再活性化が60-80%で起こる 粘膜傷害によって、疼痛、経口摂取不良、細菌・真菌の重複感染が増加する J Clin Oncol 2013;31:794-810 NCCN guideline Version 1.2018 Prevention and Treatment of Cancer-related infections
#54.
VZV感染と化学療法 細胞性免疫障害がVZV感染症の主要なリスクである 同種移植患者で抗ウイルス薬による予防しない場合、VZVの再活性化は30-60%で起こる。自家移植では約20%。 J Clin Oncol 2013;31:794-810, Ann Hematol 2014;93:677–682 NCCN guideline Version 2.2017 Prevention and Treatment of Cancer-related infections
#55.
抗ウイルス薬の効果 同種移植・急性白血病の寛解導入療法 アシクロビルの投与で HSV再活性化(口腔粘膜病変など)が減少 急性白血病の寛解導入療法で、細菌感染症(菌血症、GNR感染症、ブドウ球菌感染症)減少した アシクロビルとバラシクロビルの効果は同等 副作用はほとんどない Cochrane Database Syst Rev 2009;(1):CD006706 N Engl J Med 1981;305:63-7(RCT) BMJ 1983;287:384-8(RCT) Ann Intern Med 1983;99:773-776(RCT) BMJ 1995;310:1169-72 (RCT) Support Care Cancer 1993;1:139-144(RCT)
#56.
抗ウイルス薬の効果 同種移植患者 アシクロビル(800mg 1日2回)を移植後1年間投与 VZV再活性化が減少する(RCT:N=83) 投与終了後には、累積発症率は同等となる 同種移植・自家移植患者 アシクロビルを移植後1年間または免疫抑制薬終了まで VZV再活性化が減少する(大規模なコホート研究) 中止後のrebound現象はなかった Blood 2006;107:1800-1805 Blood 2007;110:3071-3077
#57.
まとめ アシクロビルの予防内服 効果 HSVとVZVの再活性化を減らす 対象疾患 急性白血病の寛解導入療法(HSV) 同種・自家造血幹細胞移植(HSV/VZV)
#58.
NCCNガイドライン2018 NCCN guideline Version 1.2018 Prevention and Treatment of Cancer-related infections 多発性骨髄腫、CLL、悪性リンパ腫でも推奨される状況がある
#59.
問題点 アシクロビル予防内服の保険適応 - 造血幹細胞移植患者 - 移植7日前から移植後35日まで - 200mg 1日5回 ※バラシクロビル 500mg 1日2回 AMLの寛解導入療法の場合に保険適応なし
#60.
低用量アシクロビル 低用量アシクロビル:200mg/日 長期投与:移植後1年以上(免疫抑制薬終了まで) 自家移植レシピエントでのHSV・VZV感染症予防 同種移植レシピエントでのHSV・VZV感染症予防 アシクロビルは200mg/日でよいかもれない →保険適応期間を越えた場合は低用量が検討される ただし、すべて観察研究である Int J Hematol 2015;102(2):230-7 Transpl Infect Dis 2013;15(5):457-65 Am J Hematol 2008;83(6):472-6 Int J Infect Dis 2014;19:26-32
FNの診断と必要な検査
#61.
低用量バラシクロビル バラシクロビル少量長期投与の効果 長期:移植後1年間 投与量:500mg/日 or 500mg 週3回 自家移植レシピエントのVZV感染症予防 同種移植レシピエントのVZV感染症予防 Ann Hematol 2014;93:677-682 500mg/日 観察研究 Transpl Infect Dis 2010:12:421-427 500mg 週3 観察研究
#62.
抗ウイルス薬の使用方法 アシクロビル HSV予防:400-800mg 1日2回(200mg/日) VZV予防:800mg 1日2回 ファムシクロビル HSV・VZV予防:250mg 1日2回 バラシクロビル HSV・VZV予防:500mg 1日2-3回(500mg/日) NCCN guideline Version 2.2017 Prevention and Treatment of Cancer-related infections
#63.
選択した抗菌薬 レボフロキサシン 500 mg/日 フルコナゾール 400 mg/日 代替薬:ボリコナゾール アシクロビル 400 mg×2/日
#64.
予防についてはここまでここからはFNの診断と治療です
#65.
入院後経過 化学療法開始6日目に発熱(腋窩温38.5℃)が出現。乾性咳嗽が軽度ある。発熱前日から右内頚静脈の中心静脈カテーテル(Central venous catheter:CVC)留置部に痛みがある。 【Review of systems】 頭痛なし、鼻汁なし、痰なし、胸痛なし、呼吸困難なし 腹痛なし、下痢なし、排便時の肛門部の痛みなし 排尿時痛なし、残尿感なし、頻尿なし
#66.
身体所見 全身状態:良好、意識清明 バイタル:体温38.5℃、脈拍 103 /分 整 血圧 112/61 mmHg 呼吸数 18 /分、SpO2 98%(室内気) 頭頸部:眼瞼結膜貧血あり・点状出血なし 頸部リンパ節腫大なし、上顎洞圧痛なし 齲歯なし、口腔内カンジダなし 右内頸CVC留置部に軽度の発赤と疼痛あり 胸部:呼吸音正常、心音正常 腹部:平坦、軟、圧痛なし、肝脾腫なし 四肢:皮疹なし、下腿浮腫なし、手足の視診正常
#67.
質問2診断・必要な検査・想定される診断は?
#68.
問題 提出する検査(複数回答可) ①血液検査(血算・生化学) ②血液培養 ③尿沈査・尿培養 ④喀痰培養 ⑤胸部レントゲン ⑥胸部CT ⑦その他
#69.
血液・尿検査 WBC 1,500 /μl Neut 5.0 % Hb 5.8 g/dl Ht 16.9 % Plt 8.2×104 /μl AST 10 IU/L ALT 11 IU/L LDH 117 IU/L ALP 161 IU/L γGTP 40 IU/L TP 6.5 g/dL Alb 3.0 g/dL T. Bil 0.3 mg/dl Na 140 mEq/L K 3.8 mEq/L Cl 109 mEq/L Cr 0.59 mg/dl BUN 11 mg/dl CRP 1.03 mg/dl 尿沈査:膿尿なし、細菌尿なし
#70.
Problem List #1. 発熱性好中球減少症 #2. カテーテル関連血流感染症の疑い #3. 乾性咳嗽
FNの定義とリスク評価
#71.
FNの定義 発熱: 1回の口腔温が38.3℃以上 38.0℃以上が1時間以上持続 ※腋窩温×:不正確なため ※直腸温×:腸管内の微生物の粘膜からの侵入のリスクがある ※日本臨床腫瘍学会:腋窩温37.5℃以上を採用 好中球減少 好中球500/mm3未満 48時間以内に好中球が500/mm3未満に減少すると予想される状態 Clin Infect Dis 2011;52:e56-93
#72.
注意点 FNの定義は一般的基準であって、絶対的なものではない。これらの定義を満たしてなくても、好中球減少のリスクがある期間に抗菌薬を投与を行う、という、「臨床判断」が重要である。 FNの定義は、がん薬物療法時に発熱した場合に、抗菌薬の経験的治療を行うべき患者を選定する目安であり、定義を満たさない場合でも、個々の患者の状態や背景を考慮して経験的抗菌薬治療を行うべきか判断する Clin Infect Dis 2011;52:e56-93 日本臨床腫瘍学会編 FN診療ガイドライン 改訂第2版, 2017
#73.
どのような患者でFNが起こりやすいか?
#74.
FN発症リスク FN発症リスクは 患者 腫瘍 化学療法のレジメン 治療目的 の4要素を検討する NCCN guideline Version 2.2017 Myeloid Growth Factors
#75.
FN発症リスク(患者) 65歳以上でfull doseの化学療法 化学療法または放射線治療の既往 持続する好中球減少 腫瘍による骨髄浸潤 最近の手術または開放創 肝障害(Bil > 2.0) 腎障害(CCr < 50) performance status不良 HIV感染症 NCCN guideline Version 2.2017 Myeloid Growth Factors
#76.
FNの疫学
#77.
FNの疫学 固形癌の化学療法:10-50%で発症する 血液悪性腫瘍の化学療法:80%以上で発症する 20-30%で、臨床的に感染症が確認される 好発部位は、腸管、肺、皮膚 患者全体の10-25%で血液培養陽性となる 血液培養陽性例の疫学的パターンは、1960-1970年代はGNR、1980-1990年代はGPC、現在はCNSが最多 死亡率の高い微生物:グラム陰性桿菌(緑膿菌、S. maltophilia)、Bacillus cereus etc. Clin Infect Dis 2011;52:e56-93 日本臨床腫瘍学会 FN診療ガイドライン, 2017
#78.
FN患者で分離される細菌 Clin Infect Dis 2011;52:e56-93
#79.
FN患者で分離される真菌 Clin Infect Dis 2011;52:e56-93 真菌が発熱初期の原因なることは稀。好中球減少が遷延し、経験的抗菌薬を1週間使用した後に出現することが多い Candidaは、化学療法による粘膜傷害によって粘膜バリアが傷害されると血流感染を起こす Aspergillusのなどの糸状菌は、多くの場合、好中球減少が2週間以上続いた場合に、副鼻腔や肺に感染症を起こす
#80.
FN患者の特徴
FN患者の身体所見と検査結果
#81.
身体所見・検査結果の特徴 炎症の症状/検査所見... 弱い or ないことが多い Clin Infect Dis 2011;52:e56-93
#82.
炎症所見の欠如 SSTI:硬結・紅斑・熱感なし 肺炎:胸部レントゲンで浸潤影なし 髄膜炎:髄液細胞増加なし 尿路感染症:膿尿なし という可能性があるので注意して解釈する Clin Infect Dis 2011;52:e56-93
#83.
身体所見 感染症の好発部位を慎重に診察する 皮膚 カテーテル刺入部 中咽頭(口腔内) 消化管 肺・副鼻腔 陰部・肛門周囲 Clin Infect Dis 2011;52:e56-93
#84.
初期検査 血算(分画を含む)・生化学検査 血液培養2セット以上 CVC留置中:各lumenから1セットずつと末梢血培養1セット 臨床的に疑わしい部位から培養検体 気道症状・所見がある場合、胸部X線 Clin Infect Dis 2011;52:e56-93
#85.
培養検査 血液培養 - 2セットは「基本」であり必須 便 - 下痢→CDI検査○、便培養× 尿:尿路感染症が疑わしい場合 - 尿路感染症の症状・徴候がある場合 - 尿道カテーテル留置している場合 - 尿検査で異常がみられる場合 - 提出する閾値は低くてよいと思われる Clin Infect Dis 2011;52:e56-93
#86.
培養検査 髄液 - 髄膜炎が疑われる場合 皮膚 - 皮膚病変の吸引・生検(グラム染色・培養) 呼吸器検体 - 喀痰培養:湿性咳嗽がある場合 - BAL(気管支鏡):胸部画像で原因不明の浸潤影 Clin Infect Dis 2011;52:e56-93
#87.
症例:行った初期検査 血液培養 喀痰培養 胸部単純X線
#88.
胸部単純X線写真: 明らかな浸潤影と結節影なし 喀痰グラム染色: Geckler 3 口腔内常在菌のみ
#89.
質問3外来で化学療法中にFNを発症した場合の治療場所(入院・外来)は?
#90.
原則入院 J Clin Oncol 2013;31:794-810
FNの初期治療と入院基準
#91.
入院 or 外来 基本:全例入院して点滴抗菌薬で治療 FN発症時点で、重症化リスクを評価する - 重症化リスクが高い場合は、入院治療 - 重症化リスクが低い場合は、外来治療を検討することができる J Clin Oncol 2013;31:794-810, J Clin Oncol 2018;36(14):1443-1453
#92.
重症化リスク評価 低リスク患者の抽出
#93.
高リスク群 7日間を超える著明な好中球減少が予想される 併存する医学的問題がある: 血行動態不安定 口腔・消化管粘膜障害(嚥下に影響 or 重度な下痢) 腹痛、悪心・嘔吐、下痢などの消化器症状 新たに出現した神経学的状態と精神状態の変化 CRBSI 新しい肺浸潤影、低酸素血症、慢性肺疾患の既往 肝障害:トランスアミナーゼが正常値の5倍を超える 腎障害:CCr 30 mL/分未満 MASCCスコア21点未満 Clin Infect Dis 2011;52:e56-93
#94.
MASCC score:使わない! J Clin Oncol 2000;18:3038-51 J Clin Oncol 2013;31:794-810 low-riskと判定されても、約10%が重症化し入院が必要となる
#95.
その他のリスク評価法 Talcott’s rule group IVが低リスク CISNE tool low risk: 0 intermediate risk: 1-2 high risk: ≧ 3 2点以下で外来治療検討 Br J Cancer 2011;105(5):612-7 J Clin Oncol 2015;33(5):465-71 J Clin Oncol 2018;36(14):1443-1453
#96.
低リスク群 好中球減少が7日以内 活動性の併存疾患がない 肝機能と腎機能が安定 MASCCスコア21点以上 Clin Infect Dis 2011;52:e56-93 J Clin Oncol 2013;31:794-810
#97.
外来治療の条件 低リスク群(これだけではない!) 臨床的criteriaを満たす(次スライド) 社会的条件を満たす(次の次のスライド) フルオロキノロンの予防内服をしていない J Clin Oncol 2018;36(14):1443-1453 Clin Infect Dis 2011;52:e56-93
#98.
臨床的criteria J Clin Oncol 2013;31:794-810, J Clin Oncol 2018;36(14):1443-1453 ★以下の項目がない 血圧低下 貧血 好中球100未満が7日以上 血小板の著明な減少 内服困難 吐き気・嘔吐 下痢 腹痛 フォーカスが確定 肝障害 意識変容・神経所見 頻呼吸・低酸素血症 腎不全CCr<30 など
#99.
社会的条件 綿密な観察と適切なケアへの迅速なアクセスが24時間週7日保証されている 臨床状態が悪化した場合に、患者が1時間以内に地域の医療施設を受診できる 家族または介護者が24時間家にいる 治療へのnoncompliance歴がない Clin Infect Dis 2011;52:e56-93 J Clin Oncol 2018;36(14):1443-1453
#100.
さらに... 初回治療は病院内で行う 4時間以上経過観察 問題なく経過すれば帰宅可能 最初の3日間は、毎日状態の評価が必要(訪問診療、外来受診、電話など) NCCN guideline Version 1.2018 Prevention and Treatment of Cancer-related infection J Clin Oncol 2018;36(14):1443-1453
経験的治療の選択とタイミング
#101.
ここまでクリアしてようやく外来治療可能 外来治療は あまり現実的でないと思います
#102.
外来で使用する抗菌薬 シプロフロキサシン 500-750mg 1日2回 アモキシシリン/クラブラン酸 500/125mg 1日3回 - AMPC/CVA(250/125) 1錠 1日3回 - AMPC(250) 1錠 1日3回 の併用治療が標準治療 代替薬 - レボフロキサシン 500-750mg 1日1回 - モキシフロキサシン 400mg 1日1回 Clin Infect Dis 2011;52:e56-e93 J Clin Oncol 2018;36(14):1443-1453 NCCN guideline Version 1.2018 Prevention and Treatment of Cancer-related infection
#103.
治療途中での入院 3日以内に解熱しない場合 解熱した後の発熱の再燃 新しい症状の出現 内服困難 血液培養陽性 処方した抗菌薬が無効な細菌が検出された場合 NCCN guideline Version 1.2018 Prevention and Treatment of Cancer-related infection J Clin Oncol 2018;36(14):1443-1453
#104.
基本的に全例入院
#105.
質問4FNの初期治療は?
#106.
Problem List #1. 発熱性好中球減少症 #2. カテーテル関連血流感染症の疑い #3. 乾性咳嗽
#107.
院内アンチバイオグラム
#108.
問題 FNの初期治療は(複数回答可)? ①セフェピム ②ピペラシリン/タゾバクタム ③メロペネム ④アミノグリコシド ⑤バンコマイシン
#109.
経験的治療:単剤治療 抗緑膿菌活性のあるβラクタム薬の単剤治療が推奨される(A-I) セフェピム ピペラシリン/タゾバクタム イミペネム/シラスタチン メロペネム Clin Infect Dis 2011;52:e56-93
#110.
緑膿菌カバーと単剤の背景 緑膿菌感染による死亡率が非常に高いため、抗緑膿菌活性のある抗菌薬が推奨される βラクタム単剤は、βラクタム薬とアミノグリコシドの併用治療より、有害事象が少なく、生存率は同等 Clin Infect Dis 2011;52:e56-93 Cochrane Database Syst Rev 2013: CD003038
菌血症のリスクと治療方針
#111.
治療開始のタイミング 来院後すみやかに治療開始 - 2時間以内(IDSA 2011) - 1時間以内(ASCO 2018) Clin Infect Dis 2011;52:e56-93 J Clin Oncol 2018;36(14):1443-1453
#112.
初期治療薬の選択
#113.
初期治療薬の選択 患者のリスク状態(好中球減少期間) 耐性菌リスク(個人) - 最近の抗菌薬使用(予防内服も含む) - 耐性菌検出歴 重症化リスク - 感染臓器、臨床的不安定性(shock or 臓器障害) 耐性菌リスク(local epidemiology) - 院内アンチバイオグラム、地域の耐性菌疫学パターン 薬剤アレルギー Clin Infect Dis 2011;52:e56-93 NCCN guideline Version 1.2018 Haematologica 2013;98(12):1826-35
#114.
重要な2つのポイント 耐性菌による感染症のリスク - ESBL産生菌、カルバペネマーゼ産生菌 - 耐性ブドウ糖非発酵菌 - MRSA、VRE 重症化リスク これらを検討して初期治療薬を選択 Haematologica 2013;98(12):1826-35
#115.
耐性菌による感染症のリスク 耐性菌検出歴 - colonization - 感染症 広域抗菌薬への曝露歴 重症(肺炎、sepsisなど) 長期間の入院、複数回の入院 尿路カテーテル留置 高齢 ICU滞在 Haematologica 2013;98(12):1826-35
#116.
重症化リスク 循環動態不安定(shock) 肺炎、腸炎、CRBSI 臓器障害 高齢 Haematologica 2013;98(12):1826-35
#117.
カルバペネムを検討する場合 ESBL産生菌の検出歴がある 重症な場合 使用が推奨されない状況 - 重症化リスクなし - 耐性菌による感染症リスクが低い Haematologica 2013;98(12):1826-35
#118.
経験的治療:併用治療 アミノグリコシド、フルオロキノロンの併用治療は、以下の場合に検討 - 合併症(血圧低下、肺炎) - 耐性菌が疑われる場合 - 緑膿菌感染症のリスクが高い場合 Clin Infect Dis 2011;52:e56-93 NCCN guideline Version 1.2018
#119.
経験的治療:併用治療 バンコマイシンは、 初期治療に加える標準薬としては推奨されない(A-I) Clin Infect Dis 2011;52:e56-93
#120.
FNにおける菌血症 CNSが最多! CNS coagulase-negative Staphylococci コアグラーゼ陰性ブドウ球菌
発熱持続時の追加検査と治療
#121.
バンコマイシン不要?
#122.
そう、不要! FN患者の菌血症の原因としてもっとも頻度が高いCNSは臨床状態の急速な悪化を招くことがほとんどないため、発熱時に緊急に治療対象とする必要がない 過剰な抗MRSA薬の使用のほうが問題 Clin Infect Dis 2011;52:e56-93
#123.
FNの経験的治療に抗MRSA薬を追加する適応 血行動態不安定(血圧低下、ショック) 血液培養でグラム陽性菌検出 重篤なCRBSIが疑われる場合 皮膚軟部組織感染症 MRSAとVREとPRSPの定着 放射線画像的に指摘された肺炎(IDSA 2011) 重度の粘膜障害(IDSA 2011) Clin Infect Dis 2011;52:e56-93 NCCN guideline Version 1.2018
#124.
初期治療のまとめ 緑膿菌カバー(セフタジジム以外) 基本は単剤治療 すみやかに投与 抗菌薬併用は特定の状況で考慮 - アミノグリコシド or フルオロキノロン - VCM
#125.
行った初期治療 ピペラシリン/タゾバクタム 右内頚静脈のCVC抜去
#126.
翌日... 血液培養:2/2セットでGPC cluster検出
#127.
経過 グラム陽性球菌菌血症のため、VCMを追加 培養結果(培養提出3日目) 血液:Staphylococcus epidermidis カテーテル先端:S. epidermidis 感受性:CEZ S, VCM S 培養結果みて、VCMを終了(PIPC/TAZ単剤)
#128.
しかし...発熱が遷延 治療開始5日目も発熱が持続 症状は、発熱と軽度の乾性咳嗽のみ 全身状態は比較的良好 右内頚CVC留置部の炎症所見改善傾向
#129.
質問5発熱が持続する場合追加検査は?抗菌薬は変更 or 追加?
#130.
問題 追加する検査は(複数回答可)? ①血液培養 ②喀痰培養 ③胸部CT ④βDグルカン ⑤ガラクトマンナン検査 ⑥その他
経験的抗真菌薬治療の適応
#131.
問題 追加する治療は(複数回答可)? ①経験的バンコマイシン ②経験的抗真菌薬 ③検査結果に応じて、治療薬変更・追加する
#132.
初期治療薬の変更 治療変更は、臨床データ・微生物学的データに基づいて行う 発熱だけで安定していれば、治療変更不要 4-7日発熱が持続した場合で、まだ好中球減少がまだ続く場合、経験的抗真菌薬治療検討 Clin Infect Dis 2011;52:e56-93
#133.
抗菌薬の変更・追加 FNの解熱までの中央値 HSCTを含む血液悪性腫瘍:5日 低リスクの固形癌:2日 抗菌薬の変更・追加は、発熱パターンのみよりも、臨床的変化・培養結果に基づいて決定する 持続する発熱に対するバンコマイシンの追加投与の効果はない Clin Infect Dis 2006;43:447-459 Clin Infect Dis 2003;37:382-389 Clin Infect Dis 2011;52:e56-93
#134.
発熱持続時:感染巣の検索 初期抗菌薬投与中の再度の発熱、3日を超える発熱 血液培養の再検 症状から疑われる感染症のための検査 腹痛 or 下痢 CDI:CD検査(トキシンなど) 好中球減少性腸炎の検索:腹部CT撮影 高リスク患者 侵襲性真菌感染症の検索:胸部・副鼻腔CT・真菌マーカー Clin Infect Dis 2011;52:e56-93
#135.
追加した検査 血液検査 ガラクトマンナン抗原 β-D グルカン 培養検査 血液培養再検(治療開始翌日も提出し陰性) 画像検査 胸部単純X線写真(再検) 胸部単純CT(副鼻腔を含む) 頸静脈エコー(化膿性血栓性静脈炎検索)
#136.
検査結果 ガラクトマンナン抗原:0.8 β-D-グルカン:5.0 pg/ml未満 胸部単純X線:明らかな浸潤影なし 頸静脈エコー:血栓指摘
#137.
胸部CT所見 右肺底部に多発微細粒状・分岐状陰影 細気管支炎が示唆される 気管支肺炎パターン 鑑別: - 細菌性肺炎 - 気道侵襲型肺アスペルギルス症
#138.
質問6治療を追加しますか?その場合どの薬剤を選択しますか?
#139.
問題 追加する治療は? ①ボリコナゾール ②アンビゾーム ③バンコマイシン ④リネゾリド ⑤メロペネム(変更) ⑥変更しない
#140.
抗真菌薬の追加 経験的治療 empiric therapy 先制攻撃的治療 pre-emptive therapy
侵襲性真菌感染症の診断と治療
#141.
経験的治療 empiric therapy
#142.
経験的治療 侵襲性真菌感染症の検索を進めつつ、抗真菌薬治療を開始すること 侵襲性真菌感染症の「診断」や、侵襲性真菌性感染症「らしさ」(症状・検査所見から)は問わない
#143.
経験的抗真菌薬治療 侵襲性真菌感染症のリスクが高い患者 好中球減少期間が7日より長期と予測される場合 広域抗菌薬治療に反応しない 発熱が4-7日以上持続 上記すべて満たす場合に抗真菌薬を開始する Clin Infect Dis 2011;52:e56-93, NCCN guideline Version 1.2018 Clin Infect Dis 2004;39:S38–43
#144.
経験的抗真菌薬治療 経験的抗真菌薬の効果を示した報告は2つ FNの治療開始後、4-7日間発熱が持続する患者を対象 いずれもアムホテリシンBを使用 抗真菌薬非投与群と比較 抗真菌薬投与群で - response rate(解熱など)が高い - 侵襲性真菌感染症の発症とそれによる死亡が減少 - 全死亡率は差なし Am J Med 1982;72(1):101-11, Am J Med 1989;86:668-7, Clin Infect Dis 2004;39:S38–43
#145.
侵襲性真菌感染症:高リスク 好中球減少が7-10日以上持続 同種HSCT・自家HSCTレシピエント AMLまたはMDSの導入化学療法 高用量ステロイド使用中 侵襲性糸状菌感染症の既往 など Clin Infect Dis 2011;52:e56-93 NCCN guideline Version 1.2018 J Clin Oncol 2013;31:794-81
#146.
侵襲性真菌感染症:高リスク 好中球減少が7-10日以上持続 同種HSCT・自家HSCTレシピエント AMLまたはMDSの導入化学療法 高用量ステロイド使用中 侵襲性糸状菌感染症の既往 など Clin Infect Dis 2011;52:e56-93 NCCN guideline Version 1.2018 J Clin Oncol 2013;31:794-81
#147.
抗真菌薬の選択 想定される真菌 毒性 費用
#148.
原因真菌の推定 予防に使用されている抗真菌薬 初期の症状は非特異的であり、発熱が唯一の所見のことがある 検査 血液培養 胸部CT ガラクトマンナン抗原・β-D-グルカン Clin Infect Dis 2011;52:e56-93
#149.
原因真菌の推定 抗真菌薬予防がない場合 Candidaがもっとも懸念される FLCZを使用されている場合(通常経験的治療が必要となる患者は、抗真菌薬の予防投与中である) FLCZ耐性Candida(C. glabrata, C. krusei) 糸状菌(Aspergillusが最多) Clin Infect Dis 2011;52:e56-93
#150.
抗真菌薬の選択 liposomal アムホテリシンB ボリコナゾール エキノキャンディン ミカファンギン カスポファンギン Clin Infect Dis 2011;52:e56-93 NCCN guideline Version 1.2018
先制攻撃的治療の考え方
#151.
糸状菌カバー済みの患者 すでに糸状菌をカバーする抗真菌薬の予防内服をしている患者の場合、特定の抗真菌薬を推奨するデータは不十分 -「違うクラス」の抗糸状菌活性のある薬剤 -「点滴」の抗真菌薬 に変更する(B-III) Clin Infect Dis 2011;52:e56-93 NCCN guideline Version 1.2018
#152.
経験的治療の欠点 不要な抗真菌薬の投与が危惧される 高リスクの好中球減少患者の40-50%が、抗真菌薬の投与を受けるが、実際の侵襲性真菌感染症の発症率は10-15%程度 Curr Opin Investig Drugs 2003;4:974–90 Clin Infect Dis 2011;52:e56-93
#153.
先制攻撃的治療pre-emptive therapy
#154.
先制攻撃的治療 広域抗菌薬開始後4-7日間発熱が続く患者において、以下のいずれかが存在した場合に抗真菌薬を開始する(B-II) - 臨床的に安定していない - 臨床的 or CT(副鼻腔と肺)で真菌感染所見あり - 真菌の血清学的検査陽性 - 培養からCandidaやAspergillusの検出あり Clin Infect Dis 2011;52:e56-93
#155.
真菌感染症「らしい」場合に治療開始 先制攻撃的治療
#156.
早期診断のために 血清真菌抗原 低リスク患者には推奨されない - β-D-グルカン - ガラクトマンナン抗原 胸部と副鼻腔のCT Clin Infect Dis 2011;52:e56-93
#157.
β-D-グルカン AMLまたはMDSの化学療法中の真菌感染症 - 感度:63-90% - 特異度:95%以上 陽性 Candida spp・Aspergillus spp Pneumocystis spp・Fusarium spp 陰性 Cryptococcus spp・接合菌 Clin Infect Dis 2011;52:e56-93
#158.
ガラクトマンナン抗原 陽性 - Aspergillus spp、Penicillium spp 侵襲性肺アスペルギルス症の感度 - 血液悪性腫瘍の患者 感度70%、特異度92% - HSCTレシピエント 感度82%、特異度86% 偽陰性 - 抗糸状菌活性のある抗真菌薬の使用 Clin Infect Dis 2011;52:e56-93 N Engl J Med 2009;360:1870-84 NCCN guideline Version 1.2018 Prevention and Treatment of Cancer-related infections J Infect Dis 2004;190:641-9 Clin Infect Dis 2006;42(10):1417-27
#159.
侵襲性真菌感染症:CT所見 EORTC/MSGの診断基準 下気道病変の診断には... - 以下のうち1つ以上のCT所見が必要 - halo signを伴うまたは伴わない境界明瞭な病変 - air-crescent sign - 空洞性病変 Clin Infect Dis 2008;46:1813–21
#160.
Halo sign 結節周囲のスリガラス影 IPA発症早期にみられる 出血性梗塞を反映 IPAに特異的な所見ではないが、高度な好中球減少患者では、血管侵襲型肺アスペルギルス症を示唆する RadioGraphics 2001; 21:825–837 IPA: invasive pulmonary aspergillosis
侵襲性肺アスペルギルス症の治療
#161.
IPAとCT 血管侵襲型アスペルギルス症 (大部分を占める) - angioinvasive aspergillosis - 病理:菌体の肺動脈浸潤による出血性梗塞 - CT所見:単発性または多発性の結節・浸潤影・胸膜面を底辺とする楔状影、halo sign、air crescent sign 気道侵襲型アスペルギルス症 - airway-invasive aspergillosis - 病理:菌体の深部基底膜への浸潤・気管支壁の破壊 - CT所見:斑状気管支周囲浸潤影、境界不明瞭な結節、小葉中心性結節影、tree-in-bud、スリガラス影、大葉性浸潤影 - 他の病原体による気管支肺炎との鑑別は困難 RadioGraphics 2001; 21:825–837 IPA: invasive pulmonary aspergillosis
#162.
Preemptive Therapy- Evidence -
#163.
IPAとhalo sign 診断時のCTでhalo signを認めた群では、認めなかった群より治療成績がよかった(12週間後の生存率71% vs 53%) Global Comparative Aspergillosis Study(N Engl J Med 2002;347:408-15:IPAに対するVRCZ vs AMPH-B)のdataを解析(Halo signは、61%の患者で認めた) Clin Infect Dis 2007;44:373–9 IPA: invasive pulmonary aspergillosis CT画像で初期段階のIPAを見つけて治療 →予後がよいかもしれない
#164.
経験的治療 vs 先制攻撃的治療 対象者 - 血液悪性腫瘍の化学療法または自家移植患者 - 好中球減少(500 /μL)期間が10日以上が想定 4日以上続く発熱かつ以下で先制攻撃的治療開始 - 臨床症状、CTで肺炎・急性副鼻腔炎 - GM抗原陽性(週2回測定)、アスペルギルスの定着 primary endpoint:好中球回復14日後の生存率 結果 - 死亡率は同等 - 侵襲性真菌感染症増加 - 抗真菌薬のコストが35%減少 Clin Infect Dis 2009; 48:1042–51
#165.
経験的治療 vs 先制攻撃的治療 対象者:主に同種造血幹細胞移植患者(約80%) 標準治療群:持続する発熱で経験的抗真菌薬治療開始 biomarker diagnosis群: 週2回GM抗原/アスペルギルスPCR測定 GM抗原陽性1回 or 持続する発熱→胸部CT possible/probable IAで抗真菌薬治療開始 primary endpoint:26週以内の抗真菌薬投与 結果 抗真菌薬の使用例が32% vs 15% 死亡率に差なし 診断されたIA(probable/possible):biomarker群で多かった Lancet Infect Dis. 2013;13:519-28 IA:invasive aspergillosis
#166.
先制攻撃的治療 まだ十分なevidenceはない 課題 - 開始を判断するための最適な指標 臨床所見または画像所見 vs 血清バイオマーカー - 使用するバイオマーカー(抗原検査 or PCR) - タイミング(臨床所見の発現前 or 発現後) - どの抗真菌薬が最適か - 抗糸状菌活性のある薬剤で予防中の場合の対応 Clin Infect Dis 2011;52:e56-93 NCCN guideline Version 1.2018 Prevention and Treatment of Cancer-related infections
#167.
症例の経過 侵襲性肺アスペルギルス症の典型的画像ではないが、CTで右下肺野の気管支肺炎像が指摘され、ガラクトマンナン抗原陽性であったため、侵襲性肺アスペルギルス症(気道侵襲型)として、ボリコナゾールとミカファンギンの併用を開始(6-12週間以上の治療を予定した)
#168.
侵襲性肺アスペルギルス症の治療 推奨25:IPAの初期治療は、VRCZ 推奨27:代替薬は、L-AMBとisavuconazole 推奨28:VRCZとエキノキャンディンの併用を考慮 推奨30:IPAの治療は最低6-12週間 - 免疫抑制の程度と期間 - 感染フォーカス - 疾患の進展度 推奨76:preemptive therapyは、経験的治療の代わりになりうる Clin Infect Dis 2016;63(4):e1–60
#169.
VRCZ+エキノキャンディン 対象 - 血液悪性腫瘍またはHCTレシピエント - possible, probable, or proven invasive aspergillosis 治療:VRCZ(6週間) vs VRCZ+anidulafungin - anidulafunginの併用は2-4週間 結果: probable or proven invasive aspergillosis症例において、併用群で死亡率が低い傾向にあった(統計学的有意差なし) Ann Intern Med 2015;162:81-89
#170.
質問7治療期間は?
治療期間の決定要因と指針
#171.
治療期間 臨床的 or 微生物学的に診断された感染症(B-III) - 微生物や感染巣に応じた治療期間 かつ - 好中球減少が回復する(500 /μL以上)まで - 適切な治療期間が終了、症状・所見が消失した場合で 好中球減少状態が持続している場合 →フルオロキノロンの予防内服に移行(C-III) 原因のはっきりしない発熱(B-II) - 初期治療を好中球が回復する(500/μL以上)まで Clin Infect Dis 2011;52:e56-93
#172.
治療期間 考慮する項目(通常の感染症診療と同様) - 好中球回復(これが基本) - 解熱までの期間(改善スピード) - 感染臓器 - 原因微生物 - 患者の基礎疾患 NCCN guideline Version 1.2018 Prevention and Treatment of Cancer-related infections
#173.
治療期間:ポイント 状態が安定 好中球 500 /µL以上 微生物 感染臓器
#174.
好中球がなかなか回復しない場合それまでずっと抗菌薬が必要? 疑問
#175.
治療期間短縮できる? 欧州のFNガイドラインでは... - 発熱の原因が不明な場合 - 好中球数に関係なく - 循環動態が安定 - 解熱して48時間以上経過した場合 →「抗菌薬投与終了が可能」としている Haematologica 2013;98:1826-35
#176.
How Long Study 対象:血液悪性腫瘍の化学療法(同種・自家移植を含む)中の微生物学的診断がついていないFN患者 介入群:臨床的に改善かつ解熱した後、72時間で抗菌薬終了 コントロール群:好中球回復まで抗菌薬継続 主要評価項目:抗菌薬free期間 結果:抗菌薬free期間が2.4日短縮(28日間の観察期間) 副次的評価項目の全死亡率は同等 Lancet Haematol 2017;4:e573-583
#177.
治療期間:感染臓器別 皮膚軟部組織感染症:7-14日 血流感染 グラム陰性桿菌:10-14日 グラム陽性球菌:7-14日以上 S. aureus:血液培養陰性から4週間以上 Candida spp.:血液培養陰性から2週間以上 肺炎:7-14日 アスペルギルス:6-12週間以上 Clin Infect Dis 2016;63:e1-60 NCCN guideline Version 1.2018 Prevention and Treatment of Cancer-related infections
#178.
この症例の治療期間 FN - 好中球が500 /μL以上になるまで S. epidermidis CRBSI・化膿性血栓性静脈炎 - 血液培養陰性から4週間以上 侵襲性肺アスペルギルス症 - 最低6-12週間(経過によって調整) Clin Infect Dis 2016;63:e1-60
#179.
質問8PIPC/TAZをCEZにde-escalationする?
#180.
問題 緑膿菌活性のない抗菌薬で治療できる微生物が血液培養で検出された場合De-escalationする? ①確定診断例はその時点でde-escalation ②好中球回復してからde-escalation ③最後までde-escalationしない ④FNの重症化リスクによって上記から選択
De-escalationの考慮と実施
#181.
De-escalationについての記載 推奨17:確定診断された感染症(臨床的、微生物学的)は、感染巣と微生物の感受性試験結果に対して適切な抗菌薬で治療すべきである e73:抗菌薬のスペクトラムは、解熱が得られた段階で、確定された感染症に標的を定めたものに変更可能である Clin Infect Dis 2011;52:e56-93
#182.
De-escalationについての記載 IDSA 2011は、de-escalationを推奨しているように解釈できる部分があるが、その「詳細な内容」は、記載していない de-escalationは可能だが、抗緑膿菌活性を外せる、と明確には記載していない Clin Infect Dis 2011;52:e56-93
#183.
症例の経過 ミカファンギンは2週間継続(CT所見が速やかに改善したため終了) 好中球が500 /μLを越えた時点で、PIPC/TAZからセファゾリンにde-escalation βラクタム薬は、血培陰性確認から合計4週間 ボリコナゾールは6週間投与した
#184.
Take Home Messages 化学療法開始前に感染症のリスクを評価し、適切な予防策を講じる必要がある FNと診断した場合、入院して、抗緑膿菌活性のある抗菌薬を速やかに開始する 発熱が4日以上持続する高リスク患者では、抗真菌薬の経験的治療または先制攻撃的治療を行う De-escalationは可能かもしれない
#185.
用語集 IDA:イダルビシン Ara-C:シタラビン HSV:単純ヘルペスウイルス VZV:水痘・帯状疱疹ウイルス HBV:B型肝炎ウイルス AML:急性骨髄性白血病 MDS:骨髄異形性症候群 同種移植(通称アロ allogenic):他人からの移植 自家移植(通称オート autologous):レシピエントとドナーが同じ HSCT:hematopoietic stem cell transplantation 造血幹細胞移植 HCT: hematopoietic cell transplantation 造血細胞移植 GVHD:graft versus host disease 移植片対宿主病 IPA:invasive pulmonary aspergillosis 侵襲性肺アスペルギルス症
#186.